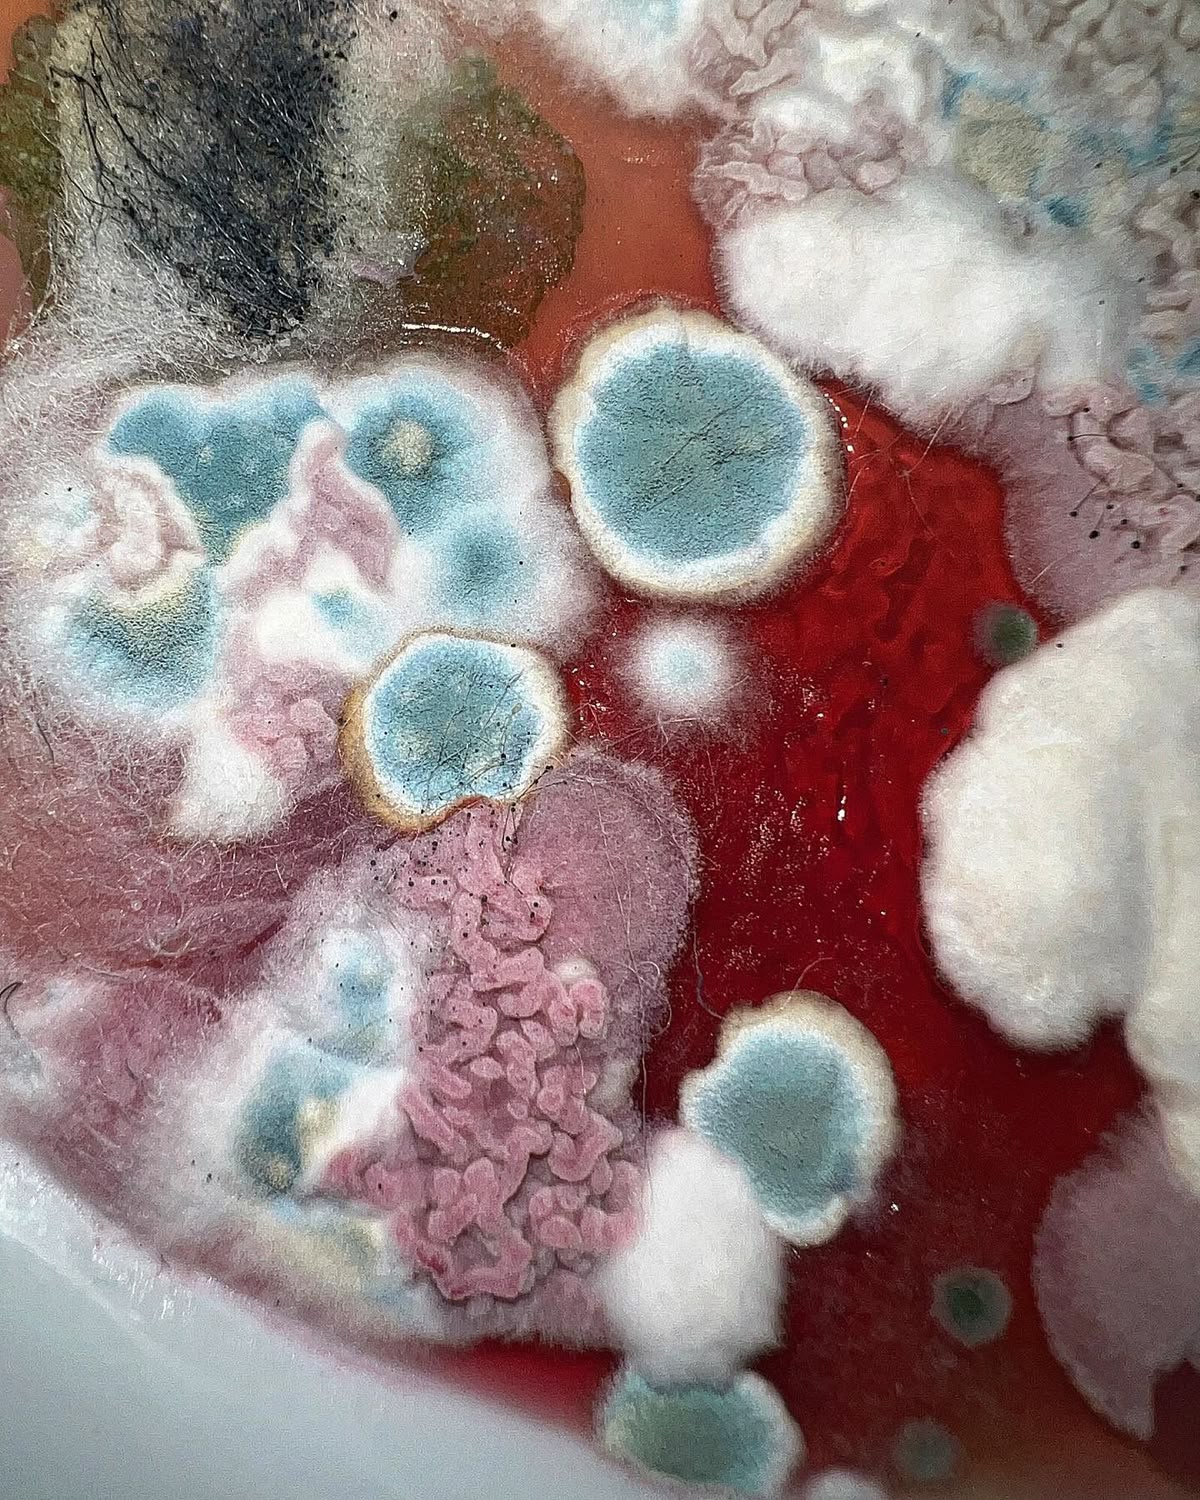

장마철은 습도가 높아 실내 공기까지 눅눅해지기 쉬운 계절입니다. 이때 가장 큰 피해를 입는 공간 중 하나가 바로 옷장입니다. 통풍이 잘되지 않는 밀폐된 옷장 내부는 습기가 쉽게 차올라 곰팡이가 번식하기 좋은 환경을 제공합니다. 곰팡이는 옷의 직물에 얼룩을 남기거나 원단 자체를 손상시키며, 심한 경우 특유의 냄새까지 발생시켜 옷을 입을 수 없게 만들기도 합니다. 더 나아가 곰팡이는 호흡기 질환이나 알레르기 원인이 되기도 하므로 단순히 외관상의 문제가 아니라 건강까지 위협할 수 있는 요소입니다. 따라서 장마철에 옷장을 안전하게 관리하기 위해서는 사전 예방이 무엇보다 중요합니다. 이번 글에서는 습기 관리, 제습제 활용, 환기 습관이라는 세 가지 핵심 전략을 중심으로 옷장 곰팡이를 완벽하게 차단하는 방법을 상세히 살펴보겠습니다.
습기 관리의 중요성
곰팡이 발생의 첫 번째 요인은 습기입니다. 일반적으로 곰팡이는 상대 습도가 70% 이상, 온도가 20~30도 사이일 때 활발하게 번식합니다. 장마철은 바로 이 조건을 충족하는 시기이므로 습도를 제대로 관리하지 않으면 옷장 내부는 곰팡이의 천국이 되기 쉽습니다. 습기를 막기 위해서는 우선 옷장의 배치부터 신경 써야 합니다. 옷장을 벽에 딱 붙여두면 통풍이 차단되어 습기가 쉽게 고일 수 있으므로, 최소 5cm 정도는 벽과 간격을 두고 설치하는 것이 좋습니다. 또한 옷장 내부에 옷을 너무 빽빽하게 걸어두지 말고, 옷 사이에 공간을 두어 공기가 흐르도록 해야 합니다. 세탁 후 보관 시에도 반드시 주의가 필요합니다. 겉보기에 마른 것 같아도 두꺼운 옷감은 내부에 수분이 남아 있을 수 있습니다. 특히 겨울 코트, 패딩, 울 소재 의류는 하루 이상 추가로 건조해야 안전합니다. 건조가 덜 된 상태에서 옷장에 넣으면 그 습기가 곧 곰팡이로 이어집니다. 습기 관리를 위해 온습도계를 옷장 근처에 두는 것도 좋은 방법입니다. 현재 습도를 수치로 확인하면 언제 제습기를 켜야 하는지, 언제 환기를 해야 하는지를 정확히 알 수 있습니다. 또한 실내에 빨래를 널어두는 것도 옷장 습도를 높이는 원인이 되므로, 장마철에는 가능하다면 빨래는 건조기를 사용하거나 환기가 잘되는 공간을 활용하는 것이 좋습니다. 이런 작은 관리들이 모여 곰팡이를 예방하는 큰 힘이 됩니다.
제습제 활용법
습기 관리의 보조 수단으로 제습제는 필수입니다. 시중에서 판매되는 제습제는 저렴하면서도 효과가 확실해 많은 사람들이 애용합니다. 옷장 구석구석에 제습제를 배치하면 내부 습기를 효과적으로 흡수할 수 있습니다. 다만 제습제는 일정 기간이 지나면 수분이 가득 차 흡수력이 떨어지므로, 눈에 보이는 물이 차올랐을 때 즉시 교체해야 합니다. 보통 1~2개월에 한 번씩 확인하는 것이 좋습니다. 옷장 크기에 맞게 적정 개수를 두는 것도 중요합니다. 작은 옷장이라면 제습제 1~2개로 충분하지만, 큰 드레스룸이라면 각 구역마다 제습제를 배치해야 효과가 고르게 나타납니다. 시중 제습제 외에도 천연 제습재료를 활용할 수 있습니다. 숯은 공기 중 습기를 흡수하는 동시에 탈취 효과까지 있어 옷장 관리에 매우 유용합니다. 숯을 망사 주머니에 담아 옷장에 걸어두면 습도 조절과 냄새 제거를 동시에 해결할 수 있습니다. 또 다른 방법으로는 실리카겔을 활용할 수 있습니다. 흔히 신발 상자나 전자제품 포장 안에 들어 있는 작은 실리카겔 팩을 모아두었다가 옷장에 두면 간단한 제습 효과를 얻을 수 있습니다. 천연 제습재로는 베이킹소다도 빼놓을 수 없습니다. 베이킹소다를 작은 통에 담아 옷장에 두면 습기를 흡수하는 동시에 곰팡이 냄새를 줄이는 효과를 줍니다. 더불어 장마철에는 옷장 바닥에 신문지를 깔아두는 것도 좋은 보조 방법입니다. 신문지는 습기를 흡수할 뿐 아니라 교체가 간편해 위생적으로 관리하기 좋습니다. 이처럼 시중 제습제와 천연 제습재를 병행해 사용하면 곰팡이 예방 효과를 극대화할 수 있습니다.
환기의 필요성과 실천법
습기 관리와 제습제 사용만으로는 곰팡이를 완벽히 예방할 수 없습니다. 가장 중요한 마지막 단계는 바로 환기입니다. 옷장은 대부분 밀폐된 공간으로 사용되기 때문에 내부 공기가 잘 순환하지 않습니다. 환기를 소홀히 하면 곰팡이는 여전히 발생할 수 있습니다. 따라서 정기적으로 옷장 문을 열어 공기를 교환하는 습관이 필요합니다. 햇볕이 드는 맑은 날에는 하루에 최소 30분 이상 옷장 문을 활짝 열어두고 내부 공기를 바꿔주어야 합니다. 주 2~3회 이상 꾸준히 실천하면 곰팡이 발생 가능성을 크게 줄일 수 있습니다. 또한 옷들을 가끔 꺼내 햇볕에 바람을 쐬어주는 것도 중요합니다. 햇빛의 자외선은 곰팡이 포자를 억제하는 효과가 있어 단순히 건조 효과를 넘어서 살균 작용까지 기대할 수 있습니다. 옷장 내부 청소도 환기의 일부로 볼 수 있습니다. 정기적으로 소독용 알코올을 묻힌 천으로 선반과 벽면을 닦아주면 눈에 보이지 않는 곰팡이 포자까지 제거할 수 있습니다. 곰팡이가 자주 발생하는 가정이라면 곰팡이 방지 코팅제를 활용하는 것도 방법입니다. 제습기를 활용하는 것도 효과적입